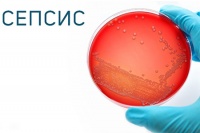
Как программа лечения сепсиса спасает жизни и снижает расходы

Низкий уровень железа в крови увеличивает риск распространения Денге
Чем больше вы страдаете анемией, тем выше вероятность того, что вы можете распространять лихорадку Денге, потому что комары, питающиеся вашей кровью, имеют больше шансов заразиться вирусом. Об этом говорит новое исследование, опубликованное в журнале Nature Microbiology 16 сентября 2019 года.